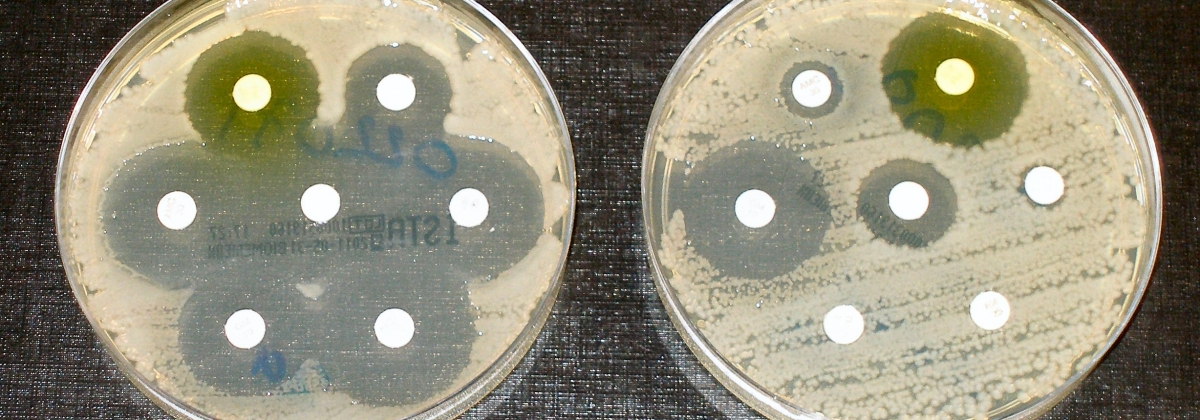
Conferencia: "Importancia de la teoría evolutiva en microbiología aplicada"

El pasado 17 de diciembre de 2020, el candidato a doctor en Biotecnología, David Borrego, que hace parte del área de investigación y desarrollo de nuestra Empresa, ofreció la video-conferencia " Importancia de la teoría evolutiva en microbiología aplicada ". El evento hizo parte del programa de capacitación continua a egresados del Departamento de Microbiología de la Universidad Popular del Cesar (UPC)".
En un principio, la charla se centra en el grupo de investigación en "Bacteriología Agrícola y Ambiental" del Instituto de Biología de la Universidad de Antioquia y en las diferentes líneas de investigación en las que viene trabajando, además de los servicios que presta. También, se da una mención especial a Inbacter, a su misión y visión de empresa de biotecnología bacteriana.
La conferencia presenta un panorama general sobre cómo la teoría evolutiva es un concepto de vital importancia, el cual toca todas las áreas de las ciencias biológicas, en especial, la microbiología. Se da una visión general del origen e importancia de la diversidad microbiana, y cómo esta está moldeada por la evolución biológica. Luego, la charla se centra en explorar las principales ideas de Charles Darwin (selección natural y ancestro común) y de cómo este en su teoría menciona a los microrganismos. Se entra a hablar de cómo la “síntesis moderna”, apoyada principalmente en la genética de poblaciones, desarrolla los conceptos de las fuerzas evolutivas (mutación, selección natural, deriva genética, flujo génico y plasticidad) y su influencia en las poblaciones microbianas, en donde se le dé una particular mención a la selección natural.
Posteriormente, la charla se focaliza en los métodos de estudio de la evolución, tanto en los comparativos como en los experimentales, pasando desde los experimentos de Luria y Delbruck hasta el de Lenski. Por último, se da un repaso general por las aplicaciones de la teoría evolutiva en la medicina (enfermedades emergentes y resistencia antimicrobiana), agricultura (prospección y selección de poblaciones) y bioprocesos (mantenimiento, domesticación y mezclas). Para finalizar, se hace énfasis en estrategias que pueden dirigir a impedir o promover la evolución microbiana.